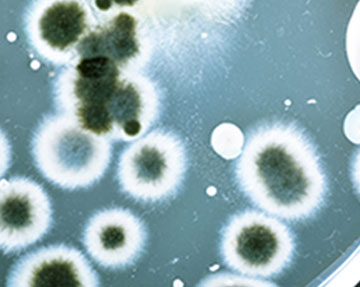

In the case study of oral sub-mucous fibrosis, the administration of placenta extract has been shown to effective, lasting and safe.
Placenta extract contains nucleotides, enzymes, vitamins, amino acids and other protein components which are essential to the body.
It acts as a ‘biogenic stimulator’ that is able to stimulate the pituitary and the adrenal cortex, helping the body to regulate tissue metabolism.
Reference: Anil S., Beena V., Oral Submucous Fibrosis in a 12-year-old Girl: Case Report, Paediatric Dentistry March/April- Vol. 16, No.2, (1993).
One study evaluated the ability of a novel natural extract of Aphanizomenon flos-aquae (AFA) enriched with phycocyanin
to protect normal human erythrocytes and blood plasma samples against oxidative damage in vitro.
In red blood cells, oxidative hemolysis and lipid peroxidation induced by the aqueous peroxyl radical generator were significantly
lowered by the AFA extract in a time-dependent and dose-dependent manner; at the same time, the depletion of cytosolic glutathione was delayed.
In plasma samples, the natural extract inhibited the extent of lipid oxidation induced by the pro-oxidant agent cupric chloride;
a concomitant increase of plasma resistance to oxidation was observed as evaluated by conjugated diene formation.
Reference: Benedetti, S., Benvenuti, F., Pagliarani, S., Francogli, S., Scoglio, S. and Canestrari, F. (2004). Antioxidant properties
of a novel phycocyanin extract from the blue-green algae Aphanizomenon flos-aquae. Life sciences, 75, 2353-2362
The Japanese National Health Insurance covers placental treatments for symptoms of menopause.
Clinical studies have proven that placenta extract can significantly reduce climacteric symptoms in pre-menopausal women without
evidential adverse effects. A human trial has reported a significant drop in KMI (Kupperman Menopause Index) only four weeks
after the administration of placenta extract.
Among the parameters of KMI score, insomnia, nervousness and weakness were crucial factors affecting the score. Clinical trials
have shown that the human body possesses excellent tolerability towards placenta extract. Blood test profiles have also demonstrated
that placenta extract did not have adverse effects on the liver, kidney or any other major organs.
Reference: Lee Y., Chung H., Kang S., Efficacy and Safety of Human Placenta Extract in Alleviating Climacteric Symptoms: Prospective,
Randomised, Double-Blind, Placebo-Controlled trial. J. Obstet. Gynaecol. Res. Vol.35, No.6:1096-1101, (2009).
Placenta extract can be used to reduce and inactivate the synthesis of the important enzyme (tyrosinase) that composes melanin.
Skin areas with postburn hyperpigmentation that is injected with intradermal injection of placenta extracts (placenta hydrolysate)
can be healed over weeks of injection. A study to estimate the effect of intradermal injection of placenta extracts (placenta hydrolysate)
to skin areas with postburn hyperpigmentation was performed. It was found that the pigment index of the injected area had decreased
significantly after 4 weeks of injection.
Direct injection of placenta extract into a wound margin can promote wound healing. The study follows with an area of skin defect
which was injected with placenta extract around the boundaries of the wound; then the research subject was measured by digital image
every 3 days over 2 weeks. Acceleration in the decrease of wound size was found from the third day to the ninth day.
Reference: Choi JS, Moon JH, Lee JY, Seo CH, Jun AY, Choi EH, Jang KU. Effect of Intradermal Injection of
Placenta Hydrolysate to Postburn Hyperpigmented Skin J Korean Burn Soc. 2009 Dec;12(2):135-138.
Reference: Hong JW, Lee WJ, Hahn SB, Kim BJ, Lew DH. The effect of human placenta extract in a wound healing model. Ann. Plast. Surg. 2010; 65: 96-100.
According to the foremost scientist in Aphanizomenon flos-aquae (AFA) research Dr. Christian Drapeau, AFA contains the unique
molecule phenylethylamine in abundance. Phenylethylamine is a compound naturally produced by the brain. It plays a major role
in the mediation of experience associated with pleasure, joy, love and awareness. When ingested orally, Phenylethylamine readily
crosses the blood-brain barrier. It acts as an endogenous neuromodulator that is capable of elevating mood and increasing alertness.
According to recent open studies, the administration of phenylethylamine rapidly improves mood and relieves depression in 60% of
depressed patients. Phenylethylamine produces sustained relief of depression in a significant number of patients, including some
unresponsive to the standard treatments. It also improves mood as rapidly as amphetamine and does not produce tolerance.
Reference:Sabelli, H., Fink, P., Fawcett, J. and Tom, C. (1996). Sustained antidepressant effect of PEA replacement.
Journal of Neuropsychiatry and Clinical Neurosciences, 8, 168-171.
Placenta extract contains rich growth factors, immunization molecules, important lipids, nucleic acids and hundreds of
other various compounds which are essential for a mother’s postpartum recovery.
Clinical studies have found that 86% of new mothers who experienced insufficiency in breast milk saw an increase in breast
milk production within days after ingesting placenta extract. This result is due to the small amount of oxytocin present in
the placenta extract. Oxytocin is known to ease birth stress and help the smooth muscles around the mammary glands to contract and produce milk.
Recent further studies also support the role of placenta as an enhancing agent in promoting pain tolerance
and preventing postpartum bleeding.
Reference: Odell J., New Perspectives of Placenta as Medicine, (2010).